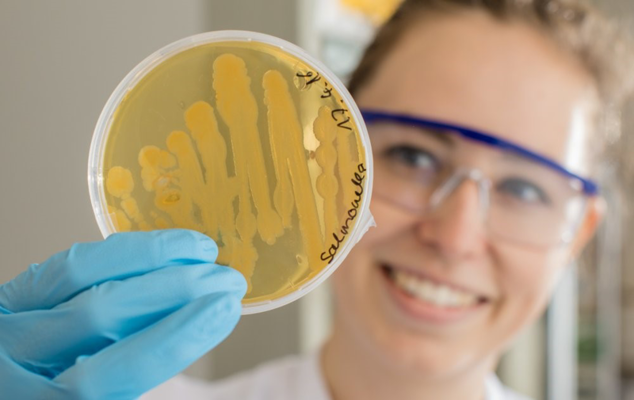

Hochschule Flensburg
Schon mal Deine DNA gesehen? Girls'Day im Bereich Bio und Food Sciences
23.04.2026|08:30 – 13:00 Uhr |freie Plätze: 11/15 |barrierefrei

08:30 Uhr Zusammenkommen mit einer Einführung in die Hochschule durch die Studienberatung.
09:15 Uhr
Die Bio and Food Sciences -Labore öffnen ihre Türen und heißen Dich herzlich willkommen.
Während du unter Anleitung von Student:innen Experimente wie z. B. die Sichtbarmachung deiner eigenen DNA durchführen kannst, lernst du die Berufswelt in einem modernen Bio-Tech-Labor und weitere Einrichtungen der Hochschule kennen und erhältst ganz nebenbei Einblick in den Studienalltag.
12:15 Uhr gemeinsames Mittagessen in der Mensa
13:00 Uhr Ende der Veranstaltung
Was solltest du mitbringen?
Bitte ziehe geschlossene Schuhe an und trage eine lange Hose. Lange Haare bitte im Labor hochbinden.
Persönliche Schutzausrüstung wird von der Hochschule bereitgestellt.
Bitte nimm ausreichend zu trinken mit.
Weitere Informationen zu unserem Angebot findest du auf unserer Website.
Dieses Angebot ist barrierefrei
Wenn du begleitende Unterstützung benötigst, melde dich bitte im Vorfeld bei uns. Bei weiteren Fragen ruf uns gerne an oder schreib eine E-Mail. Wir können dann deinen Besuch vor Ort gemeinsam planen.
Wichtiger Hinweis zur Anmeldung
Zur Teilnahme an diesem Angebot musst du mindestens 13 Jahre alt sein.
Anmeldung
Bei diesem Angebot kannst du dich online anmelden.